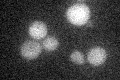

View description
Conserved NAD+ dependent histone deacetylase of the Sirtuin family involved in regulation of lifespan; plays roles in silencing at HML, HMR, telomeres, and the rDNA locus; negatively regulates initiation of DNA replication
Localization:
Intensity:
Fold change:
Significance:
-
C’ GFP library in SD
below threshold18.31 -
N' NOP1pr-GFP in SD

N/A0 -
N' TEF2pr-mCherry in SD

N/A0 -
N' NATIVEpr-GFP in SD

N/A0 -
N' TEF2pr-VC and Cyto-VN in SD

N/A0 -
C’ GFP library in SD+DTT

cytosol18.110.98No -
C’ GFP library in SD+H2O2

cytosol16.060.87No -
C’ GFP library in Starvation Media

cytosol14.30.78No -
C’ GFP library on the background of Pup2-DaMP

below threshold -
C’ GFP library on the background of CCT mutant

below threshold18.72611.02231No
